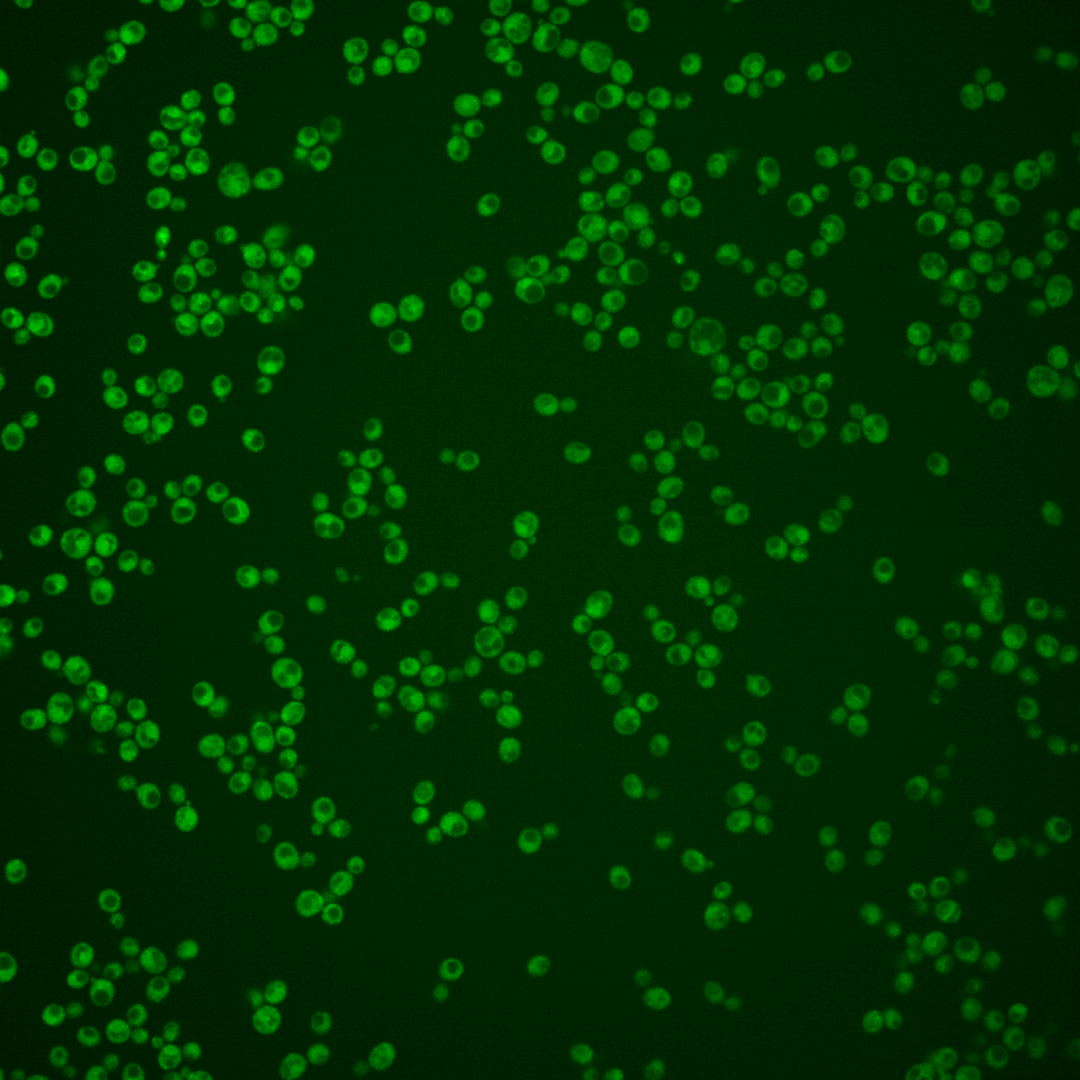
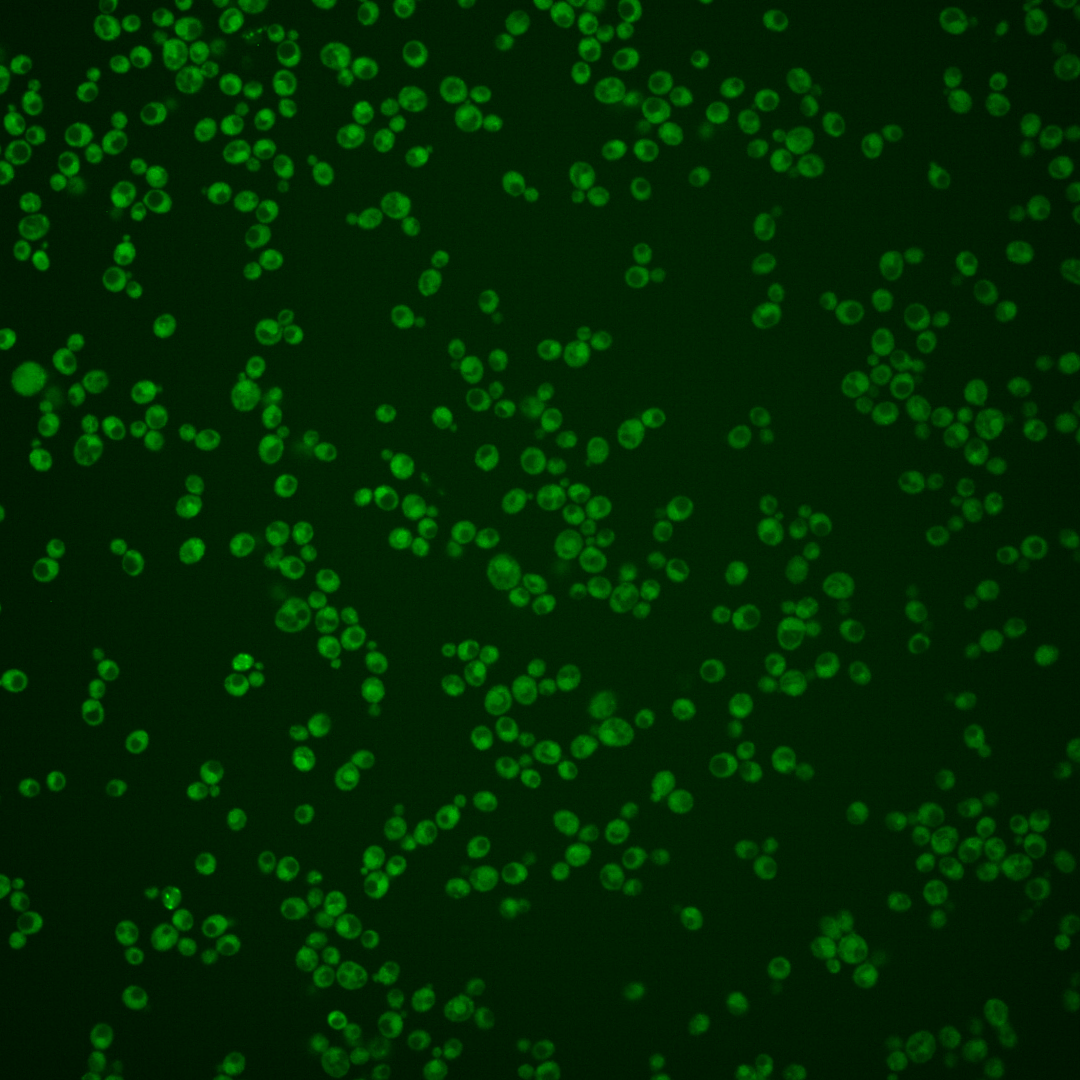
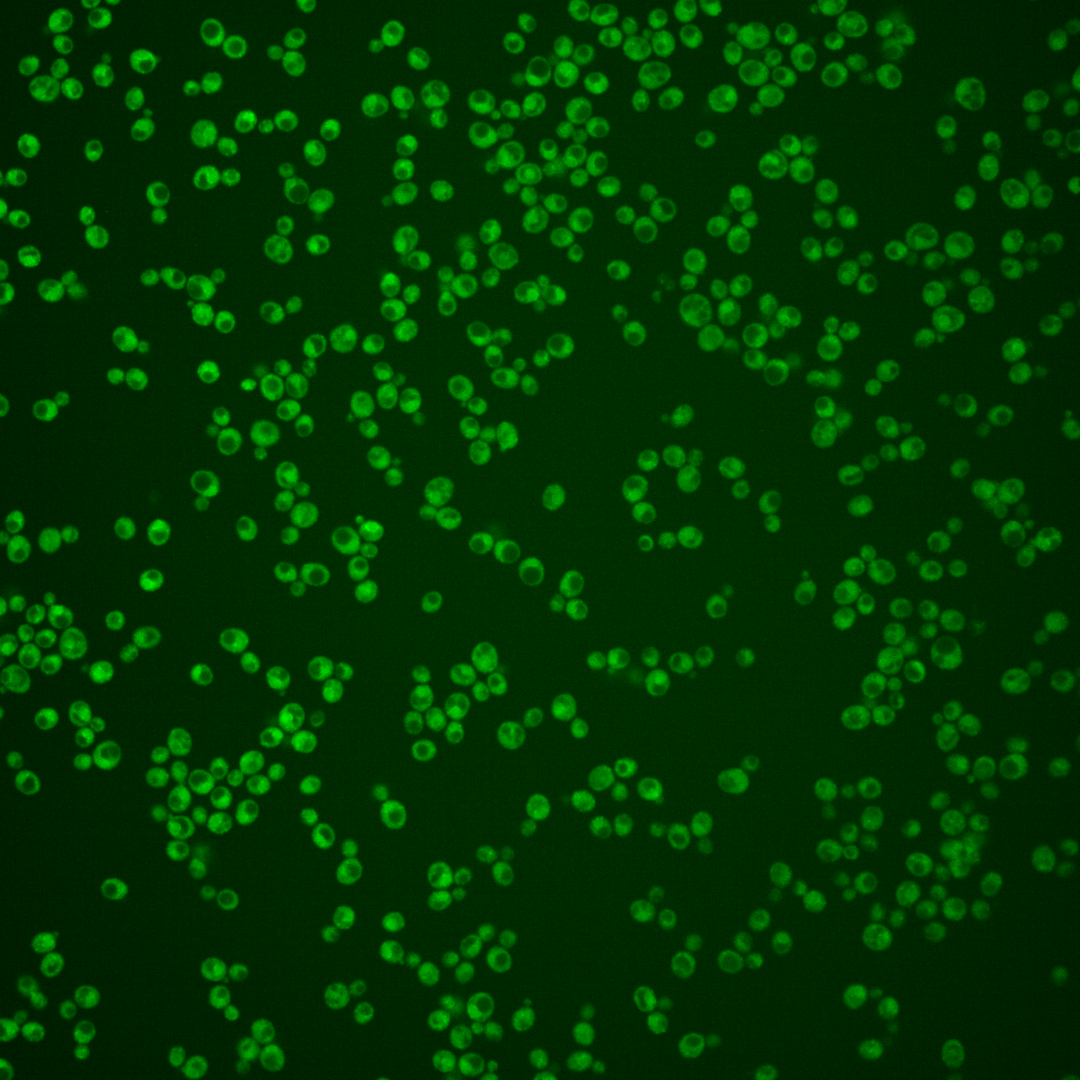
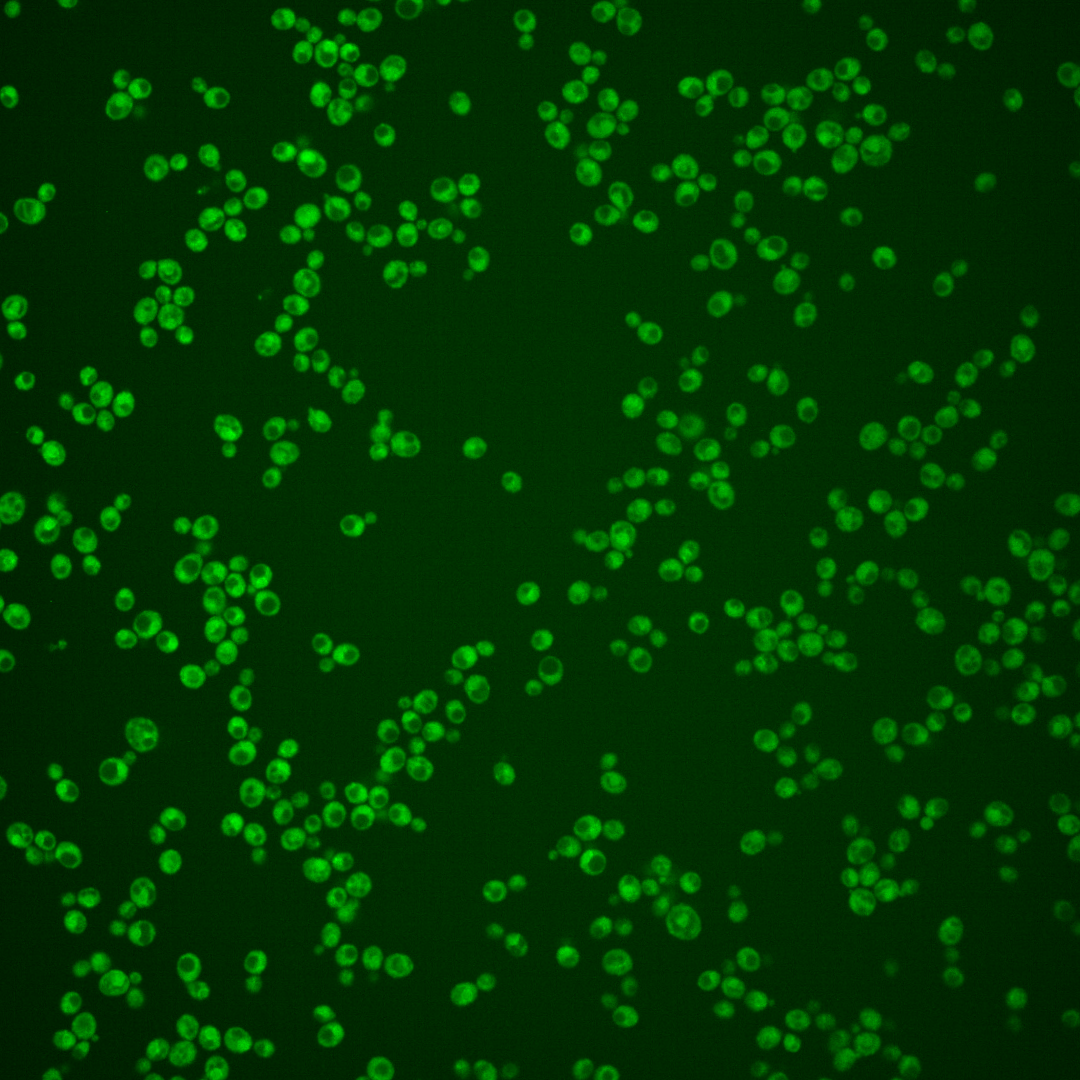
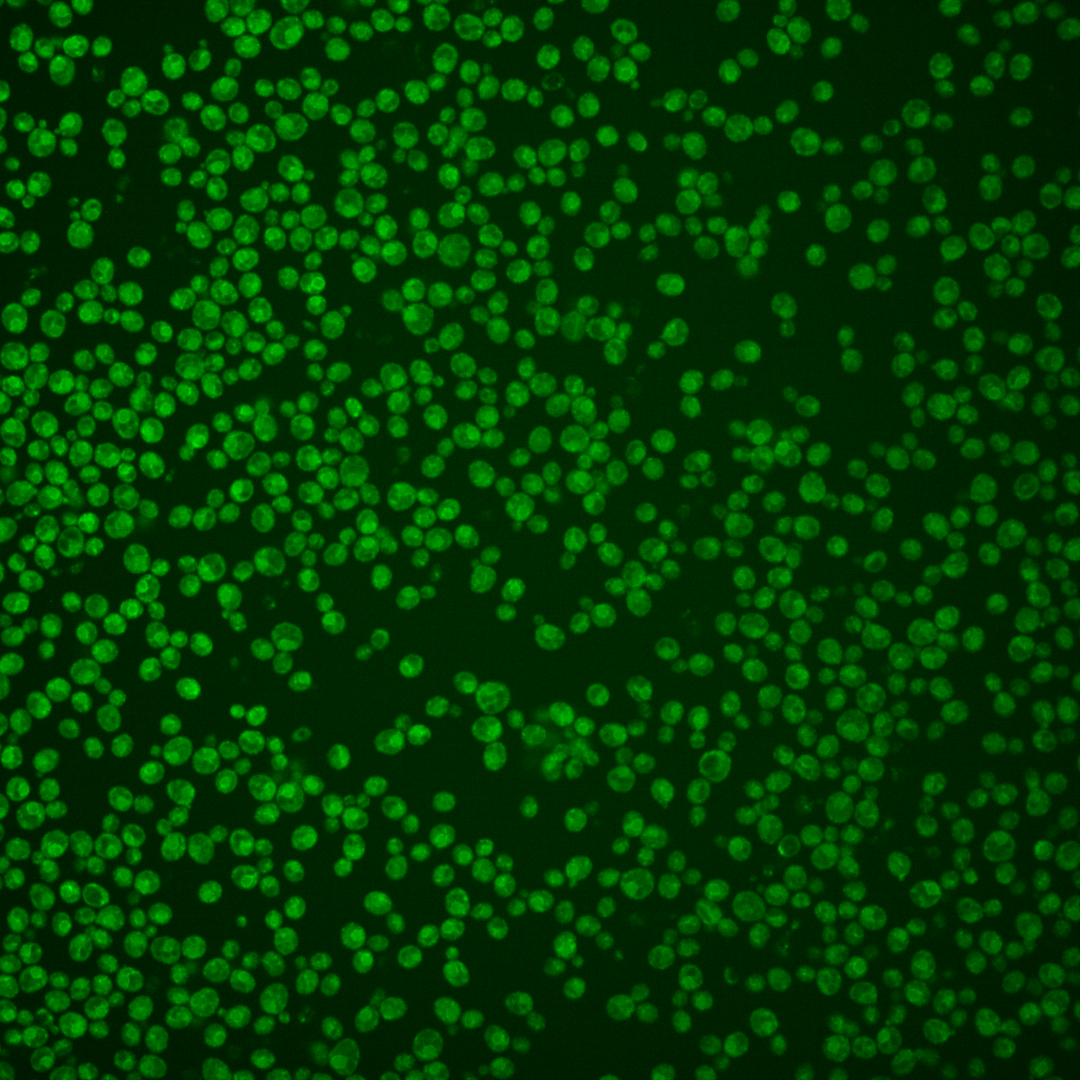
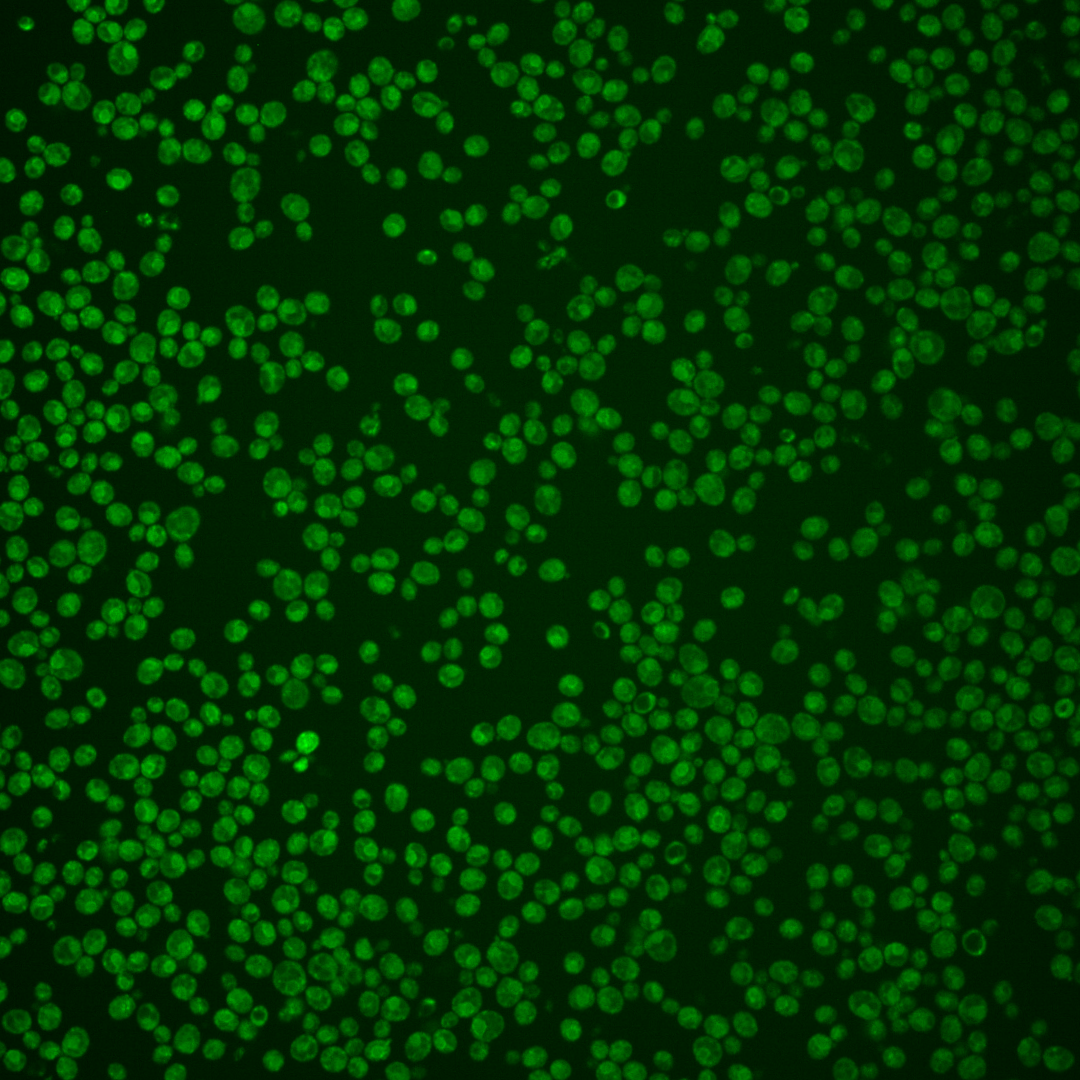

| Standard name | |
|---|---|
| Human Ortholog | |
| Description | Farnesyl cysteine-carboxyl methyltransferase; mediates the carboxyl methylation step during C-terminal CAAX motif processing of a-factor and RAS proteins in the endoplasmic reticulum, localizes to the ER membrane |
Micrographs




















































































Sub-cellular Localization
Yeast GFP Assignment
Protein Abundance
Localization Change
External localization resources
| ensLOC | DeepLoc | |||||||||||||||||||||||
|---|---|---|---|---|---|---|---|---|---|---|---|---|---|---|---|---|---|---|---|---|---|---|---|---|
| Localization | WT1 | WT2 | WT3 | RAP60 | RAP140 | RAP220 | RAP300 | RAP380 | RAP460 | RAP540 | RAP620 | RAP700 | HU80 | HU120 | HU160 | rpd3Δ_1 | rpd3Δ_2 | rpd3Δ_3 | WT1 | WT2 | WT3 | AF100 | AF140 | AF180 |
| Cortical Patches | – | 2 | 2 | 1 | 3 | 2 | 2 | 4 | 6 | 2 | 0 | 8 | 3 | 19 | 9 | 6 | 6 | 5 | 0 | 2 | 3 | 4 | 10 | 7 |
| Bud | – | 2 | 2 | 1 | 3 | 14 | 17 | 22 | 15 | 16 | 20 | 24 | 0 | 3 | 2 | 1 | 1 | 0 | 0 | 0 | 0 | 3 | 5 | 6 |
| Bud Neck | – | 0 | 0 | 0 | 0 | 0 | 0 | 0 | 0 | 0 | 0 | 0 | 0 | 0 | 0 | 0 | 0 | 0 | 0 | 2 | 1 | 2 | 3 | 5 |
| Bud Site | – | 0 | 0 | 0 | 0 | 0 | 1 | 1 | 0 | 0 | 0 | 0 | 0 | 0 | 0 | 0 | 0 | 0 | – | – | – | – | – | – |
| Cell Periphery | – | 0 | 0 | 0 | 5 | 1 | 6 | 4 | 1 | 5 | 2 | 5 | 7 | 8 | 15 | 3 | 4 | 0 | 0 | 0 | 0 | 0 | 0 | 0 |
| Cytoplasm | – | 86 | 110 | 163 | 305 | 263 | 453 | 523 | 338 | 443 | 254 | 379 | 181 | 336 | 362 | 239 | 182 | 147 | 5 | 39 | 19 | 33 | 64 | 84 |
| Endoplasmic Reticulum | – | 34 | 32 | 37 | 40 | 16 | 14 | 19 | 11 | 18 | 8 | 25 | 105 | 299 | 291 | 10 | 4 | 9 | 11 | 65 | 113 | 163 | 239 | 251 |
| Endosome | – | 3 | 0 | 4 | 13 | 4 | 9 | 8 | 11 | 13 | 1 | 3 | 0 | 5 | 1 | 5 | 8 | 11 | 0 | 3 | 3 | 15 | 37 | 45 |
| Golgi | – | 0 | 0 | 0 | 0 | 0 | 0 | 0 | 0 | 0 | 0 | 0 | 0 | 0 | 0 | 0 | 0 | 1 | 0 | 0 | 0 | 3 | 7 | 7 |
| Mitochondria | – | 1 | 2 | 1 | 5 | 7 | 47 | 35 | 47 | 58 | 56 | 99 | 0 | 0 | 0 | 13 | 6 | 1 | 3 | 5 | 10 | 17 | 21 | 17 |
| Nucleus | – | 1 | 0 | 0 | 4 | 0 | 1 | 3 | 0 | 2 | 0 | 1 | 2 | 0 | 2 | 0 | 3 | 1 | 0 | 0 | 0 | 0 | 1 | 1 |
| Nuclear Periphery | – | 0 | 0 | 0 | 0 | 1 | 2 | 2 | 0 | 1 | 0 | 0 | 0 | 1 | 0 | 0 | 0 | 0 | 0 | 1 | 0 | 2 | 3 | 5 |
| Nucleolus | – | 1 | 0 | 0 | 0 | 1 | 0 | 0 | 1 | 2 | 0 | 0 | 0 | 0 | 0 | 0 | 0 | 0 | 0 | 0 | 0 | 0 | 0 | 0 |
| Peroxisomes | – | 0 | 0 | 0 | 0 | 0 | 0 | 0 | 0 | 0 | 0 | 0 | 0 | 0 | 0 | 0 | 0 | 0 | 0 | 0 | 0 | 0 | 0 | 0 |
| SpindlePole | – | 0 | 0 | 0 | 0 | 0 | 0 | 0 | 0 | 3 | 0 | 0 | 0 | 0 | 0 | 1 | 0 | 1 | 0 | 1 | 0 | 0 | 0 | 1 |
| Vac/Vac Membrane | – | 1 | 1 | 1 | 9 | 10 | 27 | 18 | 26 | 22 | 10 | 12 | 2 | 5 | 3 | 13 | 20 | 12 | 3 | 23 | 23 | 67 | 107 | 181 |
| Unique Cell Count | 125 | 144 | 198 | 363 | 298 | 533 | 594 | 408 | 538 | 306 | 480 | 287 | 632 | 637 | 275 | 212 | 174 | 28 | 148 | 178 | 317 | 509 | 620 | |
| Labelled Cell Count | 131 | 149 | 208 | 387 | 319 | 579 | 639 | 456 | 585 | 351 | 556 | 300 | 676 | 685 | 291 | 234 | 188 | 28 | 148 | 178 | 317 | 509 | 620 | |
Yeast GFP Assignment
Protein Abundance
| Screen | WT1 | WT2 | WT3 | RAP60 | RAP140 | RAP220 | RAP300 | RAP380 | RAP460 | RAP540 | RAP620 | RAP700 | HU80 | HU120 | HU160 | rpd3Δ_1 | rpd3Δ_2 | rpd3Δ_3 | AF100 | AF140 | AF180 |
|---|---|---|---|---|---|---|---|---|---|---|---|---|---|---|---|---|---|---|---|---|---|
| Mean Cell GFP Intensity (1e-4) | – | 7.2 | 5.9 | 6.6 | 6.4 | 5.8 | 5.0 | 5.2 | 5.1 | 4.9 | 4.7 | 4.6 | 8.9 | 8.1 | 8.3 | 6.6 | 6.8 | 7.3 | 9.6 | 10.0 | 10.7 |
| Std Deviation (1e-4) | – | 1.1 | 0.7 | 1.0 | 1.1 | 1.1 | 1.1 | 1.0 | 1.0 | 0.9 | 0.8 | 0.8 | 1.1 | 1.0 | 1.0 | 1.1 | 1.1 | 1.2 | 1.4 | 1.6 | 1.5 |
| Intensity Change (Log2) | – | – | – | 0.16 | 0.1 | -0.03 | -0.24 | -0.2 | -0.23 | -0.29 | -0.34 | -0.36 | 0.58 | 0.45 | 0.49 | 0.16 | 0.2 | 0.3 | 0.7 | 0.76 | 0.85 |
Localization Change
| Localization | RAP60 | RAP140 | RAP220 | RAP300 | RAP380 | RAP460 | RAP540 | RAP620 | RAP700 | HU80 | HU120 | HU160 | rpd3Δ_1 | rpd3Δ_2 | rpd3Δ_3 |
|---|---|---|---|---|---|---|---|---|---|---|---|---|---|---|---|
| Cortical Patches | 0 | 0 | 0 | 0 | 0 | 0 | 0 | 0 | 0 | 0 | 0 | 0 | 0 | 0 | 0 |
| Bud | 0 | 0 | 1.7 | 0 | 0 | 0 | 0 | 0 | 0 | 0 | 0 | 0 | 0 | 0 | 0 |
| Bud Neck | 0 | 0 | 0 | 0 | 0 | 0 | 0 | 0 | 0 | 0 | 0 | 0 | 0 | 0 | 0 |
| Bud Site | 0 | 0 | 0 | 0 | 0 | 0 | 0 | 0 | 0 | 0 | 0 | 0 | 0 | 0 | 0 |
| Cell Periphery | 0 | 0 | 0 | 0 | 0 | 0 | 0 | 0 | 0 | 0 | 0 | 0 | 0 | 0 | 0 |
| Cytoplasm | 1.4 | 2.0 | 3.2 | 2.4 | 3.6 | 1.7 | 1.6 | 1.7 | 0.7 | -2.8 | -5.1 | -4.3 | 2.7 | 2.3 | 1.8 |
| Endoplasmic Reticulum | -0.8 | -3.3 | -5.3 | -8.3 | -8.1 | -7.5 | 0 | 0 | 0 | 3.0 | 5.5 | 5.2 | -6.0 | -6.2 | -4.5 |
| Endosome | 0 | 0 | 0 | 0 | 0 | 0 | 0 | 0 | 0 | 0 | 0 | 0 | 0 | 0 | 0 |
| Golgi | 0 | 0 | 0 | 0 | 0 | 0 | 0 | 0 | 0 | 0 | 0 | 0 | 0 | 0 | 0 |
| Mitochondria | 0 | 0 | 0 | 3.1 | 2.2 | 3.7 | 0 | 0 | 0 | 0 | 0 | 0 | 1.7 | 0 | 0 |
| Nucleus | 0 | 0 | 0 | 0 | 0 | 0 | 0 | 0 | 0 | 0 | 0 | 0 | 0 | 0 | 0 |
| Nuclear Periphery | 0 | 0 | 0 | 0 | 0 | 0 | 0 | 0 | 0 | 0 | 0 | 0 | 0 | 0 | 0 |
| Nucleolus | 0 | 0 | 0 | 0 | 0 | 0 | 0 | 0 | 0 | 0 | 0 | 0 | 0 | 0 | 0 |
| Peroxisomes | 0 | 0 | 0 | 0 | 0 | 0 | 0 | 0 | 0 | 0 | 0 | 0 | 0 | 0 | 0 |
| SpindlePole | 0 | 0 | 0 | 0 | 0 | 0 | 0 | 0 | 0 | 0 | 0 | 0 | 0 | 0 | 0 |
| Vacuole | 0 | 0 | 0 | 2.3 | 0 | 2.7 | 0 | 0 | 0 | 0 | 0 | 0 | 0 | 3.4 | 2.8 |
External localization resources
Images






























Protein Concentration and Protein Localization Data
| R1 | R2 | R3 | ||||||||||||||||
|---|---|---|---|---|---|---|---|---|---|---|---|---|---|---|---|---|---|---|
| G1 Pre-START | G1 Post-START | S/G2 | Metaphase | Anaphase | Telophase | G1 Pre-START | G1 Post-START | S/G2 | Metaphase | Anaphase | Telophase | G1 Pre-START | G1 Post-START | S/G2 | Metaphase | Anaphase | Telophase | |
| Concentration | 5.2418 | 6.3151 | 5.4903 | 5.6034 | 5.1918 | 5.5403 | 4.578 | 4.9851 | 4.7181 | 4.3072 | 4.1472 | 4.8338 | 3.3494 | 4.3876 | 3.9317 | 4.1968 | 2.983 | 3.7183 |
| Actin | 0.0207 | 0.0009 | 0.0027 | 0.01 | 0.0026 | 0.0024 | 0.004 | 0.0015 | 0.0028 | 0.0504 | 0.0002 | 0.0006 | 0.0033 | 0.0059 | 0.0012 | 0.0155 | 0.0022 | 0.0091 |
| Bud | 0.0024 | 0.0002 | 0.0003 | 0.0003 | 0.0002 | 0.0007 | 0.0002 | 0.0004 | 0.0007 | 0.0026 | 0.0002 | 0.0002 | 0.0002 | 0.0001 | 0.0003 | 0.0003 | 0.0002 | 0.0001 |
| Bud Neck | 0.0012 | 0.0009 | 0.0005 | 0.0012 | 0.0008 | 0.0013 | 0.0003 | 0.0003 | 0.0005 | 0.0012 | 0.0002 | 0.0005 | 0.0004 | 0.0015 | 0.0006 | 0.001 | 0.0004 | 0.0006 |
| Bud Periphery | 0.0018 | 0.0003 | 0.0003 | 0.0005 | 0.0002 | 0.0005 | 0.0003 | 0.0005 | 0.0007 | 0.0022 | 0.0003 | 0.0003 | 0.0005 | 0.0001 | 0.0002 | 0.0004 | 0.0003 | 0.0001 |
| Bud Site | 0.0037 | 0.0026 | 0.0006 | 0.002 | 0.0003 | 0.0003 | 0.0009 | 0.0017 | 0.001 | 0.0044 | 0.0002 | 0.0001 | 0.0006 | 0.0003 | 0.0005 | 0.0005 | 0.0004 | 0.0001 |
| Cell Periphery | 0.0005 | 0.001 | 0.0003 | 0.0003 | 0.0002 | 0.0002 | 0.001 | 0.002 | 0.0006 | 0.0008 | 0.0002 | 0.0004 | 0.0007 | 0.0004 | 0.0003 | 0.0004 | 0.0002 | 0.0001 |
| Cytoplasm | 0.2267 | 0.4214 | 0.2443 | 0.2486 | 0.3173 | 0.3356 | 0.1695 | 0.3085 | 0.1758 | 0.2563 | 0.1814 | 0.2558 | 0.1616 | 0.2885 | 0.1999 | 0.1735 | 0.2795 | 0.2062 |
| Cytoplasmic Foci | 0.0432 | 0.0287 | 0.0386 | 0.0197 | 0.0539 | 0.0347 | 0.0401 | 0.0316 | 0.0365 | 0.0347 | 0.0361 | 0.04 | 0.0282 | 0.0182 | 0.0287 | 0.0209 | 0.0164 | 0.0238 |
| Eisosomes | 0.0004 | 0 | 0 | 0.0001 | 0.0001 | 0 | 0.0002 | 0.0001 | 0.0001 | 0.0009 | 0 | 0 | 0 | 0.0001 | 0 | 0.0001 | 0.0001 | 0 |
| Endoplasmic Reticulum | 0.3085 | 0.2978 | 0.3208 | 0.3928 | 0.1693 | 0.3498 | 0.2914 | 0.3103 | 0.2613 | 0.2809 | 0.1679 | 0.2642 | 0.3685 | 0.4247 | 0.3705 | 0.1975 | 0.2428 | 0.3571 |
| Endosome | 0.1965 | 0.1594 | 0.2375 | 0.117 | 0.2612 | 0.1568 | 0.2968 | 0.1912 | 0.3388 | 0.2051 | 0.4316 | 0.3151 | 0.2514 | 0.1481 | 0.2586 | 0.2513 | 0.2444 | 0.2852 |
| Golgi | 0.0132 | 0.0056 | 0.0179 | 0.0071 | 0.0111 | 0.0076 | 0.0234 | 0.015 | 0.0265 | 0.0166 | 0.0122 | 0.0221 | 0.0172 | 0.0104 | 0.0156 | 0.0208 | 0.0081 | 0.0095 |
| Lipid Particles | 0.0233 | 0.0129 | 0.0132 | 0.0213 | 0.0076 | 0.0085 | 0.0282 | 0.0106 | 0.0147 | 0.0086 | 0.0025 | 0.0088 | 0.0142 | 0.0074 | 0.0128 | 0.0194 | 0.0027 | 0.0076 |
| Mitochondria | 0.0129 | 0.0028 | 0.0133 | 0.0046 | 0.0047 | 0.0063 | 0.0089 | 0.0103 | 0.0101 | 0.0172 | 0.0085 | 0.0066 | 0.0047 | 0.001 | 0.0022 | 0.0028 | 0.0396 | 0.0027 |
| None | 0.0128 | 0.0048 | 0.0066 | 0.0042 | 0.0256 | 0.0146 | 0.0321 | 0.0106 | 0.0248 | 0.0229 | 0.0381 | 0.0149 | 0.0034 | 0.0032 | 0.0052 | 0.0028 | 0.0009 | 0.0082 |
| Nuclear Periphery | 0.0431 | 0.0176 | 0.0287 | 0.0312 | 0.0267 | 0.0258 | 0.0258 | 0.0172 | 0.0199 | 0.0182 | 0.0173 | 0.013 | 0.0514 | 0.0353 | 0.0373 | 0.0537 | 0.0275 | 0.0323 |
| Nucleolus | 0.0013 | 0.0001 | 0.0002 | 0.0006 | 0.0023 | 0.0007 | 0.0003 | 0.0002 | 0.0001 | 0.0002 | 0.0001 | 0.0001 | 0.0002 | 0.0002 | 0 | 0.0002 | 0.0001 | 0.0001 |
| Nucleus | 0.0093 | 0.0045 | 0.0044 | 0.0053 | 0.016 | 0.0077 | 0.0026 | 0.0029 | 0.0019 | 0.0021 | 0.0021 | 0.0019 | 0.0044 | 0.0036 | 0.0031 | 0.012 | 0.0051 | 0.0038 |
| Peroxisomes | 0.0138 | 0.0002 | 0.0035 | 0.0183 | 0.0015 | 0.0009 | 0.0027 | 0.0002 | 0.0022 | 0.0049 | 0.0003 | 0.0003 | 0.0008 | 0.0002 | 0.0003 | 0.0018 | 0.0006 | 0.0002 |
| Punctate Nuclear | 0.0062 | 0.0009 | 0.0024 | 0.0026 | 0.0223 | 0.0027 | 0.0017 | 0.0005 | 0.0016 | 0.001 | 0.0005 | 0.0005 | 0.0024 | 0.0022 | 0.0006 | 0.0026 | 0.0004 | 0.001 |
| Vacuole | 0.0507 | 0.0335 | 0.0546 | 0.1032 | 0.067 | 0.037 | 0.0584 | 0.0779 | 0.064 | 0.0529 | 0.0731 | 0.0444 | 0.0749 | 0.0439 | 0.052 | 0.1918 | 0.112 | 0.0396 |
| Vacuole Periphery | 0.0079 | 0.0038 | 0.0094 | 0.009 | 0.0094 | 0.0058 | 0.0111 | 0.0064 | 0.0155 | 0.0157 | 0.0269 | 0.0104 | 0.011 | 0.0049 | 0.0102 | 0.0306 | 0.0162 | 0.0125 |
Sequencing Data
| R1 | R2 | |||||||||
|---|---|---|---|---|---|---|---|---|---|---|
| G1 Post-START | S/G2 | Metaphase | Anaphase | Telophase | G1 Post-START | S/G2 | Metaphase | Anaphase | Telophase | |
| Gene Expression | 28.3514 | 27.3993 | 18.2983 | 26.848 | 20.8631 | 13.7849 | 24.9331 | 28.0469 | 24.8885 | 31.3681 |
| Translational Efficiency | 0.8327 | 0.6288 | 0.944 | 0.5529 | 0.7827 | 1.9183 | 0.8823 | 0.4876 | 0.8732 | 0.6379 |
Hit Data
| Dataset | Hit |
|---|---|
| Protein Concentration | ✘ |
| Protein Localization | ✔ |
| Gene Expression | ✘ |
| Translational Efficiency | ✘ |
Endocytosis
| Temp | Actin Patch (Sac6-tdTomato) | Cortical Patch (Sla1-GFP) | Late Endosome (Snf7-GFP) | Vacuole (Vph1-GFP) |
|---|---|---|---|---|
| 37℃ | ||||
| RT |
Cell Cycle Omics
CYCLoPs (Ste14-GFP)
| Gene / Allele | Actin Patch (Sac6-tdTomato) | Cortical Patch (Sla1-GFP) | Late Endosome (Snf7-GFP) | Vacuole (Sac6-tdTomato) |
|---|
| Gene | Images |
|---|
| Gene | Images |
|---|
Images are not yet available
Images are not yet available